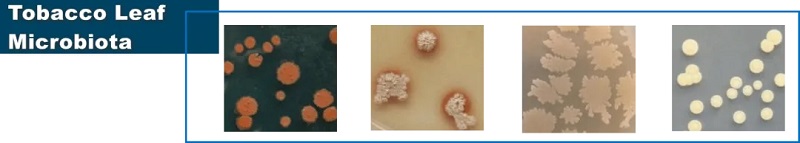

Forward-Looking Tobacco Flavorings and Fragrances Solutions

We are committed to developing tobacco flavorings and fragrances that
significantly enhance smoking comfort and deliver unique sensory experiences.
Our products comply with international standards as well as
country/region-specific regulations, ensuring safety and global market
accessibility to meet stringent requirements of domestic and international
clients.
Through years of technological accumulation, we have pioneered forward-looking innovation theories and possess multiple specialized core technologies:

Theory of Forward-Looking Innovation
Through systematic research on the cognitive mechanisms of flavor perception during smoking, Yunnan Reascend Tobacco Technology (YRTT) pioneered the Cigarette Flavor Style-Oriented Design Theory, establishing a new paradigm for tobacco flavor R&D. This theory deciphers the synergistic reciprocal activation mechanisms between olfactory-gustatory perception regions and associated brain areas, precisely identifying functional components that modulate sensory experiences. It provides a scientific basis for developing high-recognition flavor notes and guides the formulation of novel flavor compounds.
Based on this theory, we conduct innovative R&D practices:
• Continuously discovering novel natural flavor compounds/raw materials
• Developing cutting-edge tobacco flavor-blending technologies and products
These innovations expand and enhance traditional products’ functionality through synergistic effects, enriching flavor experiences with attractive aromatic characteristics, thereby empowering clients to boost market competitiveness.

Specialized Core Technologies
We possess multiple specialized core technologies in tobacco flavorings:
1. Integrated and Systematized Green Precision Extraction Technology
To isolate key aroma constituents from natural sources, we integrate green extraction techniques including:
• Supercritical CO₂ extraction
• Subcritical extraction
• Microwave/ultrasonic-assisted extraction
• Molecular distillation and chromatographic separation
We established Integrated and Systematized Green Precision Extraction Technology for diverse botanical resources, enabling full enrichment and targeted separation of key aroma compounds. Compared to conventional methods, this technology yields natural flavor products with higher purity, extended shelf life, and enhanced safety. It achieves technological breakthroughs in efficiency improvement, cost reduction, eco-friendliness, safety, and functional development & application, comprehensively establishing a technological framework based on the needs of green development.




2. Biotechnology-Driven Flavor Enhancement Technology
By collecting, isolating, screening, and identifying functional microorganisms from specialized and premium raw materials (e.g., flowers, wild fungi, tobacco plants, aromatic plants), we have systematically built a Functional Microbial Strain Resource Bank, which has been continuously expanded and optimized. Through deep biotechnology applications in reconstituted tobacco, tobacco raw materials (eg., stems, low-grade leaves, redried leaves), and functional flavors, Yunnan Reascend Tobacco Technology (YRTT) has developed the Biotechnology-Driven Flavor Enhancement Technology and its associated product lines, which offer both universal applicability and targeted functionality, establishing a proprietary biotech development and application system.

3. Structuralized Reassembly Technology for Key Natural Aroma
Constituents
We achieve high-selectivity enrichment of target aroma constituents and relevant flavor precursors through localized cleavage and precise separation of key aroma constituents in natural aroma raw materials. Using Structuralized Reassembly Technology, we stereoscopically reconstruct characteristic flavor notes, creating flavor systems with richer sensory profiles and more distinctive layers. This technology enhances the richness and expressiveness of natural flavors, designing distinctive flavor styles with high recognition and brand identity based on scientific insights and analysis.
